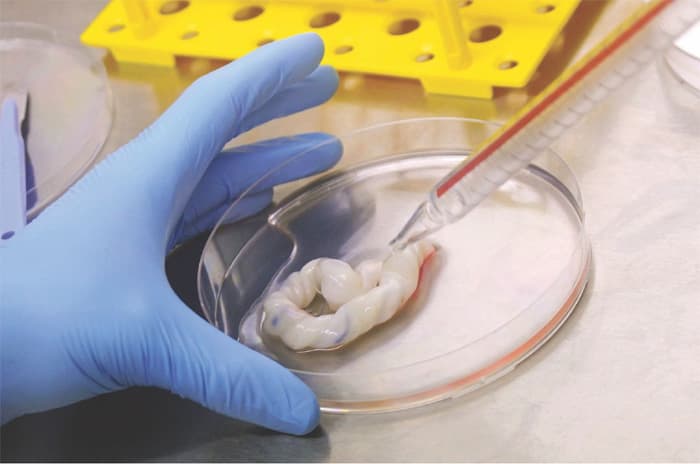
- Image

Rabu, 4 Maret
#sel punca
Berita Terkini
Kesehatan
20 November 2025, 22.17 WIB
Pimpin World Stem Cell Summit 2025 di Amsterdam, Dorong Penataan Ekosistem Sel Punca Global
20 November 2025, 22.17 WIB
Health Issues
15 Oktober 2025, 04.32 WIB
Kimia Farma Bersama RSCM Perluas Pelayanan Terapi Stem Cell di Daerah
15 Oktober 2025, 04.32 WIB
Health Issues
26 Agustus 2025, 02.49 WIB
Harapan Baru Kedokteran Regeneratif Indonesia Lewat Kolaborasi dan Inovasi Riset Ilmiah
26 Agustus 2025, 02.49 WIB
Kesehatan
26 Januari 2025, 22.34 WIB
Celltech Stem Cell Centre Hadir di Makassar, Terobosan Sel Punca untuk Masa Depan
26 Januari 2025, 22.34 WIB
Kesehatan
12 November 2024, 00.19 WIB
Seksolog Dokter Boyke Sebut Sel Punca Dapat Atasi Disfungsi Ereksi
12 November 2024, 00.19 WIB
Health Issues
15 Juli 2024, 22.31 WIB
PT Cordlife Persada Gaet Regenic untuk Hadirkan Stem Cell Berkualitas Tinggi
15 Juli 2024, 22.31 WIB
Kesehatan
13 Juni 2024, 17.41 WIB
Ahli Sel Punca Unair Dianugerahi WIPO Award for Inventor dari Kemenkumham
13 Juni 2024, 17.41 WIB
Health Issues
12 Desember 2023, 14.52 WIB
Prodia StemCell Indonesia Resmikan Gedung ACT-PLab ProSTEM di Jakarta
12 Desember 2023, 14.52 WIB
Internasional
18 Februari 2022, 15.01 WIB
Perempuan di AS Dinyatakan Sembuh dari HIV Lewat Terapi Sel Punca
18 Februari 2022, 15.01 WIB

JawaPos.com adalah bagian dari Jawa Pos Group, perusahaan media terkemuka di Indonesia. Menyajikan berita terkini, akurat, dan terpercaya.
Graha Pena Lt.2 Jl. Raya Kby. Lama No.12, Grogol Utara, Kec. Kebayoran Lama, Kota Jakarta Selatan, Daerah Khusus Ibukota Jakarta 12210
021-53699659 | 021-5349207 (Fax)
- Nasional
- Kabinet Merah Putih
- Hijrah Ramadan
- Surabaya Raya
- Sepak Bola Indonesia
- Entertainment
- Berita Daerah
- Lifestyle
- Ekonomi
- Sports
- Internasional
- Jabodetabek
- Oto Dan Tekno
- Features
- Kesehatan
- Hobi & Kesenangan
- Opini
- Sisi Lain
- Ternyata Hoax
- Humaniora
- Sepak Bola Dunia
- Art Space
- Minggu
- Wisata Dan Kuliner
- Arsitektur Dan Desain
- Ibu Kota Baru
- Infrastruktur
- Zodiak
- Kepribadian
- Islami
- Parenting
- Kuliner
- Jawa Pos 75 Tahun
- Photo
- Hello Campus
©2026 PT JAWA POS GRUP MULTIMEDIA